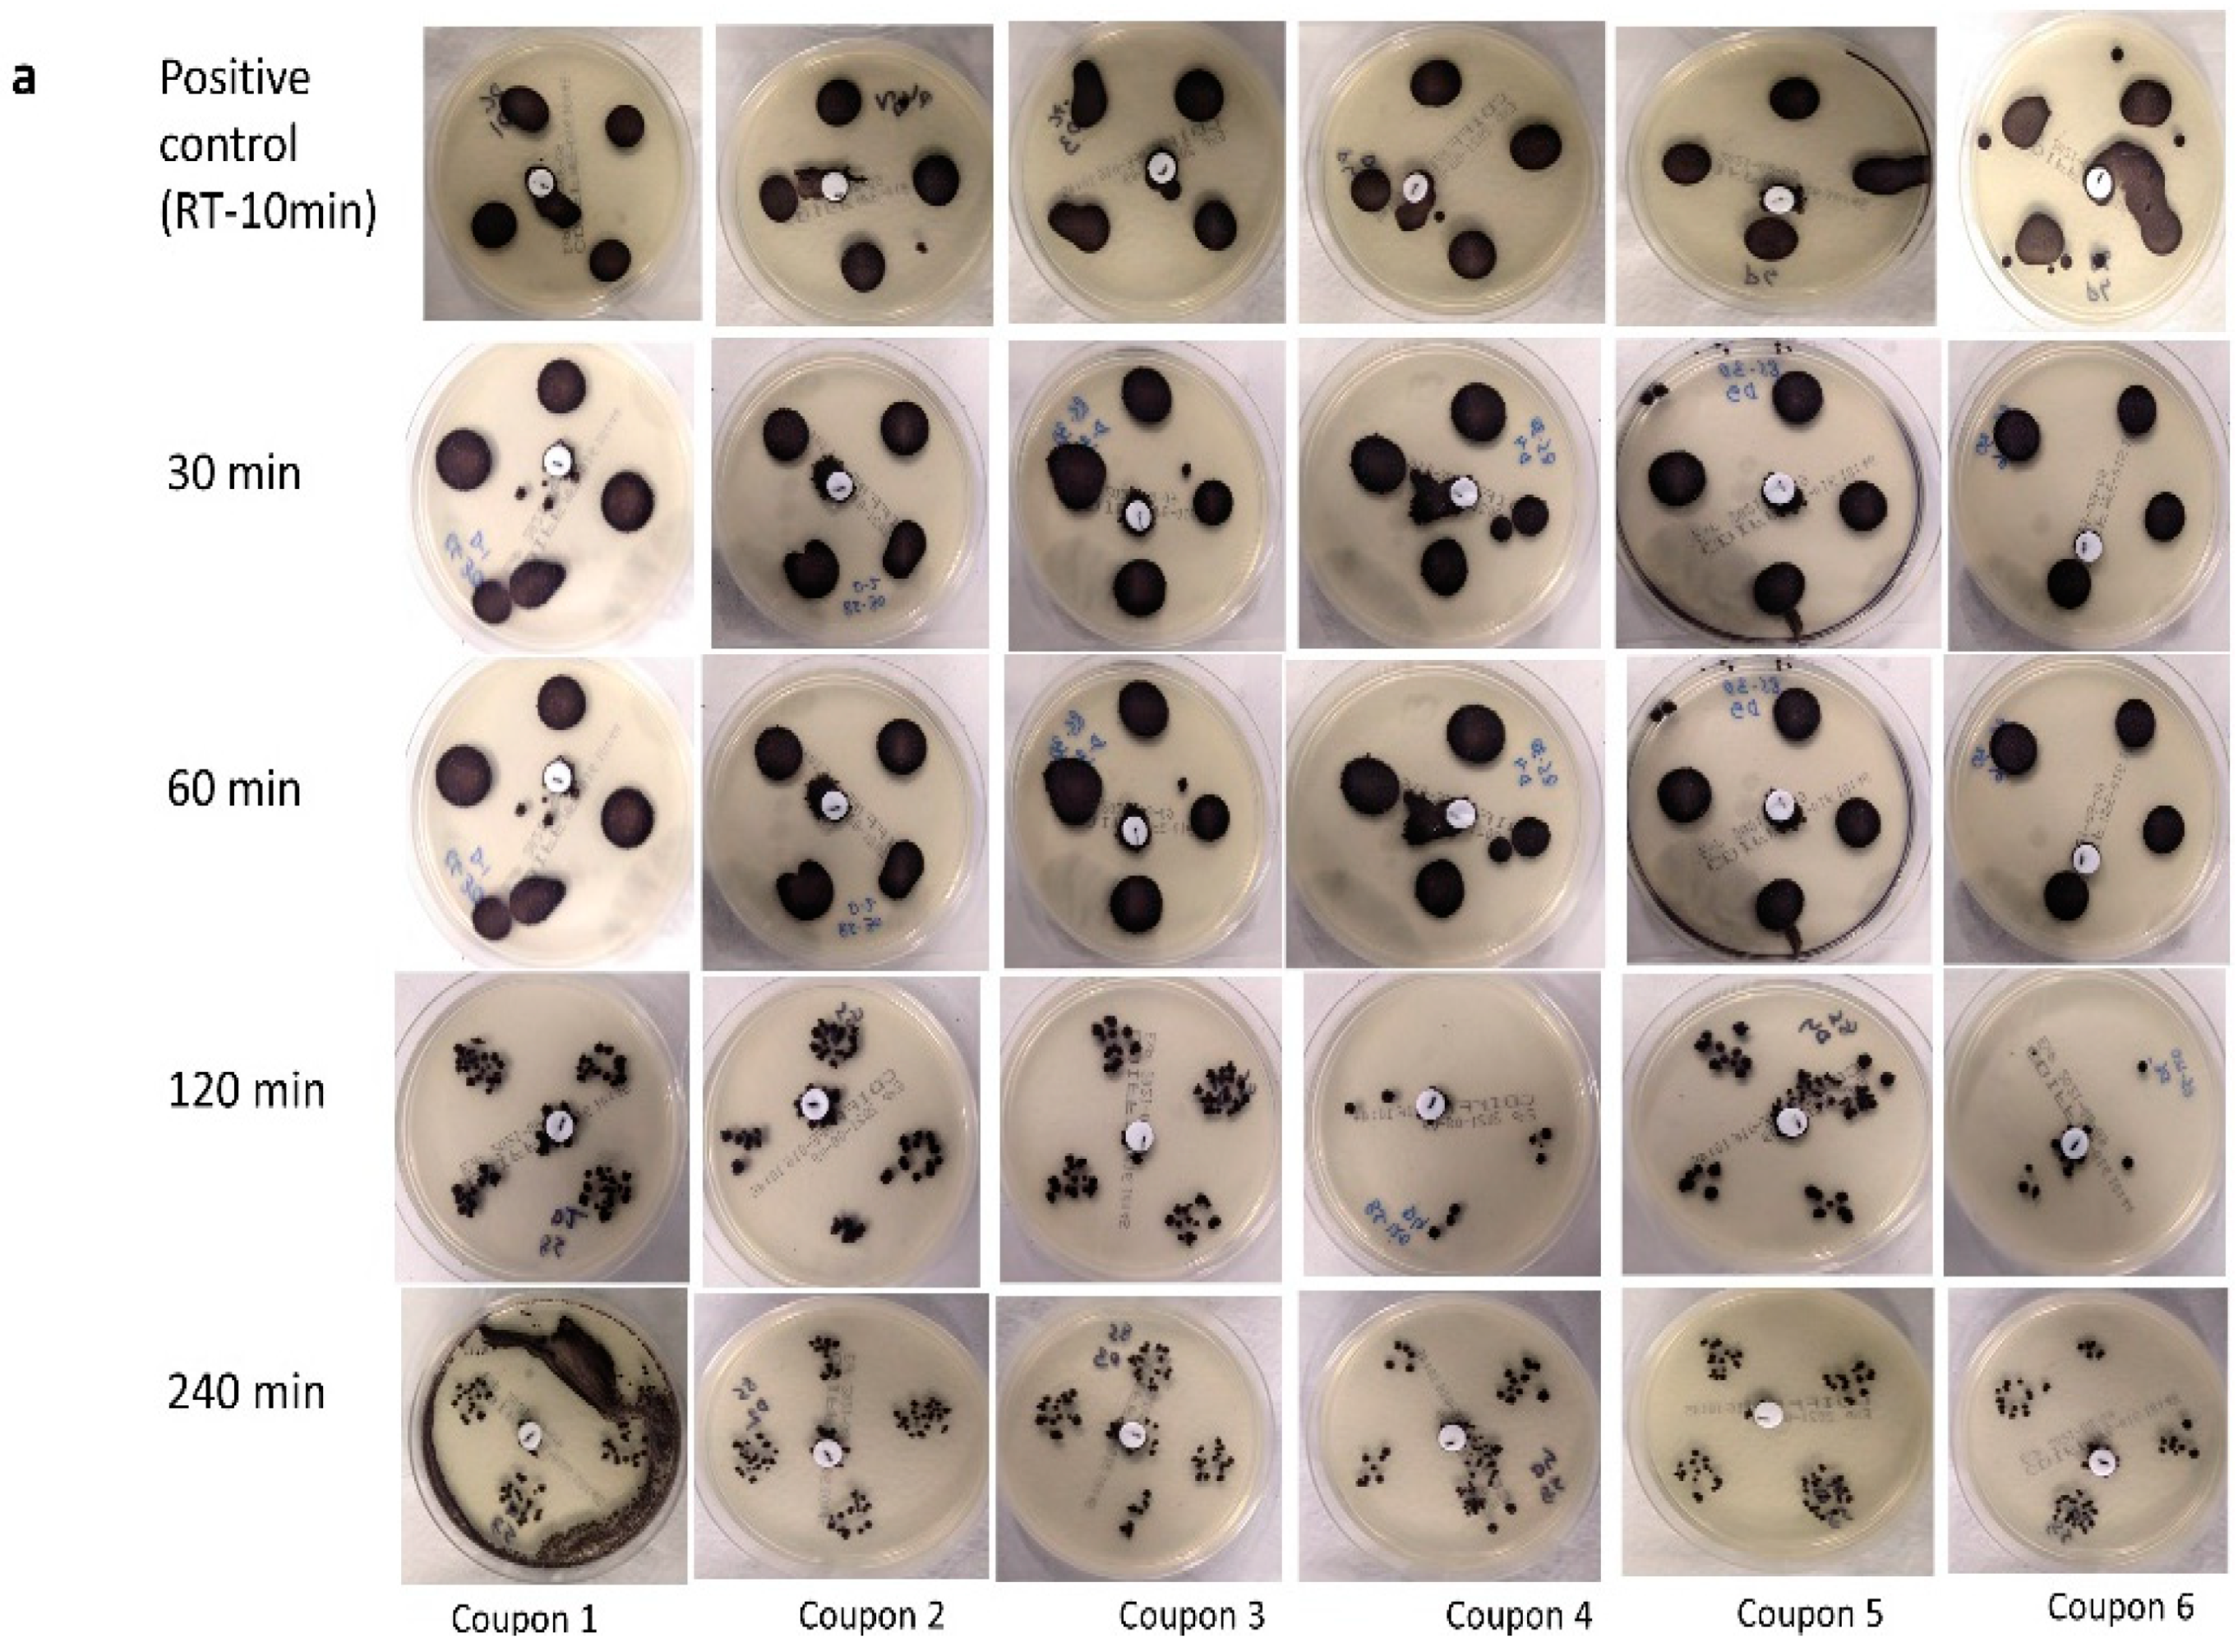

42 source of spores coupon
moldhelpforyou.com › mold-resistant-building-materialsThe Best Mold Resistant Building Materials To Mold Proof A ... Jul 28, 2019 · Use non paper faced gypsum wallboard, water resistant fiberglass facing gypsum wallboard or panels, or cement board. These products may provide more resistance to moisture and mold than regular dry wall faced with paper. This is because paper facing provides a food source for mold. airfiltersdelivered.comAir Filters for Your Home | Air Filters Delivered Easily find and purchase the right air filters online for your home at Air Filters Delivered. Shop standard, hard-to-find, and custom sizes in MERV 8, 11, and 13.
healthyandhygiene.com › blogs › newsChamomile Tea Side effects, Benefits, and Facts - Research ... Apr 08, 2021 · People with a history of severe allergies, especially spores: Chamomile could also be contaminated with pollen from alternative plants, therefore will cause issues such as allergies and asthma. Infants and young children: Chamomile tea, equal to honey and a few alternative natural merchandise could also be contaminated with gastrointestinal ...

Source of spores coupon
Online Pharmacy | Buy Prescription Drugs Online ... Buy prescription medicine online from a generic medicine supplier like RRX with useful information about active ingredients, indications, side effects, contraindications, precautions, and drug interactions. We take content accuracy seriously so that we can be your trusted source of medical information. Safe Payment Methods (Secure Payment Modes) magicshroomstore.co.ukBuy Magic Mushrooms Online in UK Shipping Discreet | UK ... Choose from a huge selection of psilocybe cubensis ‘magic mushroom’ spores. Rare and exotic psilocybe spore syringes. Fast & Free Shipping. UK source for premium Psilocybe Cubensis magic mushroom spores, offering fast discreet shipping and high-quality products. Gourmets, Grow Kits, Cultures. aaaheatingac.comTrusted HVAC Service In Kent, Auburn & Puyallup | AC & Heating Many people don’t realize that indoor air can be more polluted than outdoor air. That’s why indoor air quality services are a must. The AAA Heating & Air team can help reduce germs, mold spores, dust, chemicals, and other pollutants in your home to help you breathe easier.
Source of spores coupon. › allergies › allergy-basicsAllergy Basics: What Happens During an Allergic Reaction? - WebMD SOURCES: Asthma and Allergy Foundation of America. National Institutes of Health. American Academy of Allergy Asthma and Immunology. Medline Plus: "Allergic Reactions." aaaheatingac.comTrusted HVAC Service In Kent, Auburn & Puyallup | AC & Heating Many people don’t realize that indoor air can be more polluted than outdoor air. That’s why indoor air quality services are a must. The AAA Heating & Air team can help reduce germs, mold spores, dust, chemicals, and other pollutants in your home to help you breathe easier. magicshroomstore.co.ukBuy Magic Mushrooms Online in UK Shipping Discreet | UK ... Choose from a huge selection of psilocybe cubensis ‘magic mushroom’ spores. Rare and exotic psilocybe spore syringes. Fast & Free Shipping. UK source for premium Psilocybe Cubensis magic mushroom spores, offering fast discreet shipping and high-quality products. Gourmets, Grow Kits, Cultures. Online Pharmacy | Buy Prescription Drugs Online ... Buy prescription medicine online from a generic medicine supplier like RRX with useful information about active ingredients, indications, side effects, contraindications, precautions, and drug interactions. We take content accuracy seriously so that we can be your trusted source of medical information. Safe Payment Methods (Secure Payment Modes)

Post a Comment for "42 source of spores coupon"